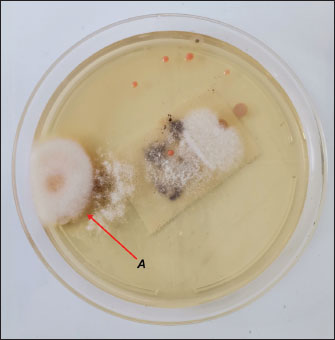

| Research Article | ||
Open Vet. J.. 2025; 15(10): 5097-5107 Open Veterinary Journal, (2025), Vol. 15(10): 5097-5107 Research Article Prevalence of Fusarium sp. in juvenile olive ridley sea turtles (Lepidochelys olivacea) kept at the Centro de Conservación Marina, Taxisco, Santa Rosa, GuatemalaLuis S. Figueroa1*, Jacqueline Escobar2 and Martín Yllescas31Facultad de Medicina Veterinaria y Zootecnia, Escuela de Medicina Veterinaria, Universidad de San Carlos, Guatemala City, Guatemala 2Departamento de Microbiología, Facultad de Medicina Veterinaria y Zootecnia, Universidad de San Carlos, Guatemala City, Guatemala 3Departamento de Patología Anatómica y Clínica, Parque Zoológico Nacional La Aurora, Ciudad de Guatemala, Guatemala *Corresponding Author: Luis S. Figueroa. Facultad de Medicina Veterinaria y Zootecnia, Escuela de Medicina Veterinaria, Universidad de San Carlos, Guatemala City, Guatemala. Email: figueroaluis565 [at] gmail.com Submitted: 11/10/2024 Revised: 25/08/2025 Accepted: 20/09/2025 Published: 31/10/2025 © 2025 Open Veterinary Journal
AbstractBackground: The olive ridley sea turtle (Lepidochelys olivacea) is experiencing population declines due to both anthropogenic impacts and emerging biological threats, including fungal pathogens such as Fusarium spp. Aim: This study aimed to determine the prevalence of Fusarium spp. in juvenile L. olivacea individuals housed at the Centro de Conservación Marina (CCM) in Guatemala. Methods: Seventeen juvenile turtles (aged 4 months to 2 years) were sampled using intentional surface swabbing. Samples were cultured on Sabouraud dextrose agar with chloramphenicol and incubated under two different conditions: 25°C for 15 days and 30°C for 7 days. Fungal colonies were analyzed both macroscopically and microscopically. Results: Fusarium spp. was identified in only one of 26 total samples (3.84%). Other fungi, yeasts, and molds were present in all specimens, indicating the presence of diverse but largely non-Fusarium fungal species. Conclusion: The low detection rate of Fusarium spp. suggests that it is not a common component of the skin flora of juvenile L. olivacea at CCM. However, its presence warrants continued surveillance given its potential role as an opportunistic pathogen under stress or immunosuppression. Keywords: Culture, Fungus, Fusarium, Prevalence, Lepidochelys olivacea. IntroductionThere are seven extant species of marine turtles currently described, among which the olive ridley sea turtle (Lepidochelys olivacea) is the most common and has a pan-global distribution and migratory behavior through major oceans (Bowen et al. 1997; Convention on Migratory Species, 2014). Despite this, L. olivacea is cataloged as ‟Vulnerable” and is experiencing population decline (Abreu-Grobois and Plotkin, 2008; CONAP, 2023); along with other species of sea turtles, it is predicted to face extinction within this century (Stanford et al., 2006; Rhodin et al., 2018). However, over recent decades, long-term conservation efforts have led to an upward trend in nesting events (Ariano-Sánchez et al., 2020). This ecological and conservation significance makes L. olivacea an interesting species for generating information on pathogenic agents capable of causing disease in both sea turtles and other marine organisms (Geroge, 1996). Medical data for these species are often overlooked, yet they are essential for addressing reproductive imbalances and indirectly maintaining the health of marine coastal ecosystems. Sea turtles play critical ecological roles as sentinels of ocean health, stabilizers of food webs, controllers of populations, and contributors to nutrient cycling (Carpena-Catoira et al., 2022). Furthermore, protecting these species improves ecotourism and environmental education outcomes, as demonstrated by Tisdell and Wilson (2005) in Australia, where in situ education increased public awareness of sea turtles’ ecological roles and conservation needs. The worldwide decline of the marine turtle population has been driven by a combination of interrelated anthropogenic (Casale et al., 2010) and environmental threats (Lalovar and Wyneken, 2020). Historically, one of the primary pressures has been the harvesting of eggs for human consumption and local trade (Santidrián Tomillo et al., 2008). Additional threats include intentional capture, incidental bycatch, and degradation and loss of nesting and foraging habitats (Casale, 2011; Santos et al., 2011; Hatase et al., 2013). Recently, the alteration of sand temperatures and moisture at nesting beaches, which affects hatchling sex ratios, has become a new reproductive threat (Laloë et al., 2016; Binhammer et al., 2019; Kuschke et al., 2024a). On Guatemala’s volcanic beaches, sand temperatures regularly exceed both pivotal (~30.5°C) and lethal (~35°C) thresholds, rising by ~1.5°C near concrete, increasing embryonic mortality and extreme feminization, highlighting the impact of urbanization on incubation (Lolavar and Wyneken, 2020; Ariano-Sánchez et al., 2023). The growing concern over emerging infectious diseases, which have become increasingly prevalent in recent decades, is compounding these threats (Bengis et al. 2004; Rodríguez-Prieto et al., 2015). Different stressors can compromise immune function in marine turtles (Hartzheim et al., 2023), making them more susceptible to pathogens such as bacteria (George, 1996; Donnelly et al., 2016; Greene et al., 2021; Sagasiousman and Khairani, 2021; Khafagy et al., 2023), viruses (George, 1996; Leineweber et al., 2021), and fungi (Nardoni and Mancianti, 2023). These pathogens have been spreading among several turtle populations, often in areas heavily impacted by human activity (Becker et al., 2015; Faust et al., 2018). The role of emerging diseases as a conservation threat is becoming more pronounced as these cumulative stressors interact, urging for integrated research to address both traditional threats and the rise of disease in marine turtle populations (Abreu-Grobois and Plotkin, 2008; Poti et al., 2021; Shanker et al., 2021; Cáceres-Farias et al., 2022; Martins et al., 2022; Kuschke et al., 2024a). Reptile fungal infections are mostly reported in terrestrial reptiles, such as snakes, lacertids, and non-marine chelonians (turtles, tortoises, and terrapins), although marine species are not exempt (Geroge, 1996; Alfaro et al., 2008; Sarmiento-Ramírez et al., 2014). Dermatophytes, dimorphic or filamentous fungi, and yeasts are the main fungal agents involved (Rautemaa-Richardson and Richardson, 2017). These infections typically affect the tegument, respiratory tract, and gastrointestinal system (Shourie et al., 2021). Several reports have documented mycoses caused by a wide range of fungal agents that affect both wild and captive sea turtle specimens (Nardoni and Mancianti, 2023). Infections have been recorded through various routes of entry and transmission, leading to outcomes ranging from mild superficial lesions to severe cases involving pneumonia or systemic infections (Cabañes et al., 1997; Manire et al., 2002; Luangsa-ard et al., 2011; Williams et al., 2012; Donnelly et al., 2015; García-Hartmann et al., 2017; Arpini et al., 2019; Wang et al., 2021). Particular attention has been drawn to the impact of Fusarium species on the reproductive success of marine turtles. According to Kuschke et al. (2023), Fusarium infections have been associated with decreased reproductive efficiency in sea turtles, and it must be regarded as essential to perform research in young specimens to better understand how these fungi may affect them in early life stages. Studies by Gleason et al. (2020), Lai et al. (2020), Pietroluongo (2023), and Wei (2023) reported that the biggest clinical consequences of Fusarium in L. olivacea embryonic and fetal stages include embryonic death, incubation failure, and unsuccessful hatching. Fungal infections present a variety of clinical signs in adult turtles, including obstructive tracheitis, superficial and deep pneumonia, systemic infection, skin and shell mycosis, and abscess formation (Nardoni and Mancianti, 2023). Fusarium may be particularly important due to its opportunistic, cosmopolitan, and saprotrophic nature (Stacy et al., 2021). These characteristics make Fusarium a potentially emergent infectious agent, especially threatening immunocompromised demographic groups such as hatchlings and juveniles of marine turtles (Garcia-Hartmann et al., 2017; Stacy et al., 2021). Recently, interest in studying fungal microorganisms affecting various life stages of L. olivacea has grown, with reports documenting the presence of different fungal genera (Nursyam et al., 2016; Chai et al., 2023; Praja et al., 2023). However, few studies have evaluated the presence of Fusarium spp. in L. olivacea populations in Guatemala and are limited to studies of nest sites (Hernández Pelén, 2020). To date, no data are available regarding the presence and effects of Fusarium infections in juvenile turtles within the country. In response to this knowledge gap, the aim of this study is to determine the prevalence of Fusarium sp. in juvenile olive ridley sea turtles (L. olivacea) kept at the Centro de Conservación Marina (CCM), Taxisco, Guatemala. Materials and MethodsStudy areaAn observational, transsectional, and descriptive study was conducted at the Centro de Conservación Marina, located at kilometer 137.5 between Iztapa and Monterrico in Taxisco, Santa Rosa, Guatemala, Central America (13.9142°N, 90.5728°W) (Fig. 1).
Fig. 1. Map showing the southern part of Santa Rosa in the Pacific coast of Guatemala, where the Centro de Conservación Marina (CCM) is located and where this study was performed. Turtle identification, housing, and pool distributionThe study was conducted on 17 neonatal L. olivacea. They were housed in four different cylindrical pools (hour: 0.78 m; d: 1.78 m) located outdoors in facilities approximately 20 m from the sea. Each pool contained four specimens each (except for pool number 5, which had only one juvenile turtle). The pools had a polypropylene mesh cover 3 m over them to protect them from direct sunlight. Each pool had a capacity of 1 700 l (449 gallons), and water was changed every day and obtained directly from the sea using a water pump and a tube network that provided water to each pool. In between water changes, a pool cleaning protocol was followed by a caretaker using sodium hypochlorite as the main disinfectant, and turtles were kept in a remnant of the old water in smaller containers, always maintaining groups together and unmixed, while the cleaning procedure was performed. As environmental enrichment, palm leaves and some tree branches were placed inside each pool. The same caretaker performed daily feeding following instructions provided by the nutrition department. During the day, the turtles were on display to visitors, who could get close to the pools but were not allowed to touch the specimens. The caretaker measured and weighed each turtle weekly to record its growth, and each specimen was cleaned of any algae growing on the surface using only a soft toothbrush unique to each group to avoid cross-contamination. Turtles were identified with non-toxic white markers on the carapace, markings from numbers one to eight using the costal and vertebral scutes. Identification marks were renewed regularly, keeping the same number for each turtle. SamplingWe considered the complete population of olive ridley sea turtles at the CCM (n=17). The study was conducted by intentional sampling, and the obtained data were analyzed both descriptively and quantitatively. To collect samples and avoid cross-contamination, sampling was performed using a pair of sterile latex gloves for handling each turtle and a face mask. Each turtle’s body surface was first rinsed with sterile water, followed by swabbing the body surface of every specimen with sterile cotton swabs. One of the authors handled the turtle while the other took the samples. Subsequently, each sample was streaked onto identified plates with Sabouraud dextrose agar + chloramphenicol, and each turtle was immediately returned to its respective pool. Each plate was identified using a permanent marker with the ID of each turtle and the pool where the specimen was living. Mycological culture and fungal identificationOnce all turtles were swabbed, the obtained samples were transported in a cooler to the CCM laboratory for incubation in a Vevor XHC-25 incubator (Vevor, Shanghai, China) at 25°C for 15 days. After that fortnight, the colonies that had grown were analyzed macro and microscopically, considering macroscopical analysis characteristics such as color, texture, size, borders, and consistency. For microscopical analysis, a piece of scotch tape was used to collect a piece of the colony from the plate and was placed over a slide to be stained with lactophenol blue. Using an optic microscope, Boeco BM-117 (Boeckel + Co, Hamburg, Germany), each sample was analyzed using objectives 40x and 100x. On the same day as the first reading, another sample was taken following the same procedure. It was only possible to collect 10 samples at this stage due to the death of some specimens. Due to culture overgrowth during the first attempt, the incubation parameters were changed to 7 days at 30°C. After a week, the same procedure for the reading was performed. Results were recorded with photographic evidence in a Google Drive folder separated into the first and second reading folders. Ethical approvalThe management of the technical department of PZNLA authorized the use of sea turtles for this study. All applicable international, national, and institutional guidelines for animal welfare were followed. This article does not contain any studies performed by any of the authors with human participants. ResultsA total of 26 samples were analyzed over two separate sampling sessions to detect the presence of Fusarium spp. The initial reading comprised 17 samples, all of which yielded negative results for Fusarium based on macro and microscopic evaluations. Due to non-fungal-related mortalities, only 9 specimens were available for the second reading. A single sample tested positive for Fusarium (Figs. 2 and 3), corresponding to an overall prevalence of 3.84% (Table 1 and Fig. 4). Various other fungal genera were also observed, including Geotrichum, Pseudallescheria, Candida, and Blastomyces, although their identification fell outside the primary scope of this analysis.
Fig. 2. The plate where Fusarium growth was identified macroscopically after the second sample incubation (7 days at 30°C). The colony on the left has a white border and a brown center with a cottony aspect (A).
Fig. 3. Microscopic view of the suspected Fusarium growth with the 100x objective colored with methylene blue. (B) The characteristic half-moon and septate shape of the macroconidia can be observed.
Fig. 4. Distribution of Fusarium spp. detection across two sampling readings. The chart reflects the absence/presence across both sets of readings. Data are derived from Table 1. Table 1. Summary of Fusarium detection across two readings in L. olivacea samples. Turtle IDs are listed under their respective pool numbers. A dash (“-”) indicates that the specimen was not available for the second reading. “Yes” or “No” under the Fusarium column indicates the presence or absence of the fungus.
DiscussionThe detection of Fusarium spp. in only one of the 26 turtle specimens analyzed suggests a low prevalence of this fungal genus within the sampled population. This single case, representing a positivity rate of 3.84%, was observed during the second sampling period and is likely indicative of sporadic environmental exposure rather than a widespread infection. All specimens tested negative in the initial reading, and no clinical signs of fungal disease were observed, aligning with reports in which Fusarium appears as an opportunistic rather than a primary pathogen in reptiles (George, 1996; Shourie et al., 2021; Stacy et al., 2021). However, the identification of Fusarium is important because of its pathogenic potential under certain conditions (Harrison, 2017; Hartzheim et al., 2023; Nardoni and Mancianti, 2023; Nash and Ryan, 2023). Further monitoring and broader sampling are recommended to determine whether this occurrence reflects a background environmental presence or an emerging risk. Methodological considerationsSome methodological factors should be considered when interpreting the findings of this study. The limited sample size (n=17 in the first reading; n=9 in the second) primarily reflects seasonal constraints. The study was conducted in May, which is the period preceding the main nesting and hatching season of L. olivacea in Guatemala, which spans from July to December (Morales-Mérida et al., 2023). Outside this season, natural hatching events are rare or absent, resulting in a noticeably reduced availability of specimens. In addition, rehabilitation and conservation facilities generally do not retain a significant number of young turtles outside the active hatching season, further constraining potential sample access. These factors collectively limited the number of available specimens. Future research should pursue broader collaborations across institutions to expand sampling efforts. The use of sterile water to rinse the turtle body surfaces before sampling was intended solely to remove debris without compromising the fungal viability of the specimens and was carefully considered. Given that sterile water lacks antimicrobial properties and does not alter pH (Instituto Nacional de Higiene “Rafael Rangel”, 2007; Centers for Disease Control and Prevention, 2008), it is unlikely to have impacted fungal recovery. Temperature adjustments during incubation also played a role. Initial incubation at 25°C, based on established protocols where optimal growth temperature ranges from 20° to 30° (Balajee, 2009; Mohsen et al. 2016; Chai et al., 2023; Praja et al., 2023), yielded no Fusarium growth. Therefore, a shift to 30°C, aligning with local environmental temperatures (Hernández Pelén, 2020), was implemented for the second reading, resulting in successful isolation. This adjustment emphasizes the importance of aligning culture conditions with ambient environmental parameters to optimize fungal recovery. The use of Sabouraud dextrose agar with chloramphenicol (SDA + Chloramphenicol) in this study was based on previous reports that successfully isolated Fusarium from sea turtle samples (Balajee, 2009; Mohsen et al. 2016; Chai et al., 2023; Praja et al., 2023) while Potato Dextrose Agar, Komada’s medium, and Modified Komada’s (Nash-Snyder) medium are considered more ideal for selectively promoting the growth of Fusarium, SDA + Chloramphenicol in this study was selected for its practicality where access to more selective media may be limited . The fungal identification method was based on morphological characteristics and provided practical and accessible preliminary data, which are particularly valuable in settings where molecular diagnostics are limited (Balajee et al., 2009). However, morphological methods are limited by species variability, operator expertise reliance, and environmental influences on colony morphology (Vyzantiadis et al., 2012; Walsh et al., 2018). While morphological identification remains suitable for preliminary screening, future studies should incorporate molecular techniques to achieve species-level precision; molecular identification was considered for this study, but the technique is not yet available within the country. External factors influencing the resultsEnvironmental and host-related factors may also have influenced fungal presence. Regular human handling, cleaning protocols, and water source quality can affect turtles’ exposure to potential pathogens. High-frequency disinfection routines may reduce microbial loads in aquatic environments, thereby affecting fungal colonization opportunities. On the other hand, frequent human interaction can induce stress in specimens, leading to immunosuppression (Hunt, 2019), which could increase susceptibility to opportunistic infections, leading to death of specimens from other causes. The body condition scores of sampled specimens were generally low (2–3 out of 9 based on adapted visual assessment from Thomson et al., 2009), resulting in the specimens’ compromised immune state. Additionally, infestations by copepods (Balaenophilus sp.) were identified following the analysis and correlation with lesions reported by Crespo-Picasso et al. (2017), which likely caused further physiological stress and skin lesions, compounding vulnerability to secondary infections and leading to premature death of specimens. Postmortem examinations revealed no other major lesions other than those caused by copepods and poor body condition. However, detailed histopathological analysis was not possible at the time, besides a microscopical identification of copepods, leaving the precise causes of mortality undetermined. Future investigations should include complete necropsies and tissue analyses to strengthen conclusions regarding causes of mortality in juvenile turtles. Broader context and implications of the studyDespite the isolated finding, the detection of Fusarium underscores the importance of environmental monitoring, especially considering climate change and its potential to reshape pathogen dynamics within marine ecosystems (Pörtner and Gutt, 2016). As migratory species, sea turtles are increasingly exposed to novel pathogens and environmental stressors resulting from anthropogenic pressures (Santidrián Tomillo et al., 2008; Casale, 2011; Santos et al., 2011; Poloczanska et al., 2013; Hatase et al., 2013; Laloë et al., 2016; Faus et al., 2018; Binhammer et al., 2019; Lalovar and Wyneken, 2020). Additionally, the early-life microbiome of L. olivacea remains poorly characterized, which represents an important research gap. Microbial communities on the skin and carapace are likely influenced by environmental conditions and could serve as indicators of habitat quality (Kuschke et al., 2024b). The development of baseline microbiome profiles could aid in future ecological and health assessments. Adopting a One Health perspective, which recognizes the interconnectedness of animal, human, and environmental health, is critical (World Health Organization., n.d.), with the potential emergence of fungal pathogens, such as Fusarium, the necessity of integrated surveillance efforts spanning multiple disciplines needs to be emphasized (Sáenz et al., 2020). Although Fusarium spp. was detected in only one juvenile L. olivacea, its identification emphasizes the importance of continuous monitoring of the environment and health of marine turtle populations. The findings suggest that even sporadic fungal presence warrants attention, particularly under physiological stress, immunosuppression, or environmental contamination conditions (Mashkour et al., 2020). This study provides a new context for pathogen detection in species conservation by addressing methodological constraints and external influencing factors. Water quality parameters should also be considered to correlate the impact of said factors on the results; when this study was conducted, the authors had no access to the required equipment nor the budget to do so. The results reinforce the importance of integrating veterinary, ecological, and environmental perspectives to better understand emerging health risks in marine species. In doing so, the study contributes to a One Health approach and supports the need for expanded surveillance efforts in the face of evolving ecological challenges (Aguirre et al., 2002; Mashkour et al. 2020). ConclusionAlthough Fusarium spp. was detected in only one specimen (3.83%), this study establishes an important foundation for understanding fungal exposure in juvenile L. olivacea in Guatemala. The findings highlight the importance of establishing ongoing epidemiological surveillance, proposing diagnostic approaches, and adopting a broader ecological perspective to safeguard the health of sea turtles in a rapidly changing marine environment. Given the migratory nature of L. olivacea, its global distribution, and the potential for interspecific interactions facilitating pathogen transmission, monitoring the emergence of fungal diseases such as Fusarium has become increasingly important. Considering the growing impact of climate change on marine ecosystems, continued epidemiological surveillance efforts are crucial to understanding how marine species are being affected and how they are adapting to new health challenges. This study is an essential first step toward filling critical knowledge gaps in marine turtle health and supports conservation efforts under the One Health framework (Aguirre et al., 2002; Mashkour et al., 2020). Several environmental and management factors, including pool cleaning protocols (materials, frequency, etc.), water source and change schedules, handling practices, and environmental temperature, could have influenced the results. Incubation conditions, including timeframes and temperature adjustments, should be carefully considered in future studies to optimize fungal recovery. AcknowledgmentsThis research was performed thanks to the close collaboration between the Parque Zoológico Nacional La Aurora (PZNLA), Guatemala City, Guatemala, the Centro de Conservación Marina (CCM), Taxisco, Santa Rosa, Guatemala, and the agreement between PZNLA and the Facultad de Medicina Veterinaria y Zootecnia, University of San Carlos, Guatemala, to provide senior year students for the Supervised Professional Exercise (EPS, by its Spanish acronym). We express our deepest gratitude to Rowland K. Griffin for his invaluable collaboration in the development of this work and to Darrewth Styven Reynosa for English language editing. Their generosity in sharing knowledge, insightful feedback, and determined support were essential to this study. Conflicts of interestThe authors have no conflicts of interest to declare. This study has been used as a requirement to obtain the degree in Veterinary Medicine. FundingThis study received no specific grant. Author’s contributionsLSF and MY contributed to the conception and design of the study. LSF and MY performed material preparation, data collection, and analysis. LSF wrote the first draft of the manuscript, and all authors commented on previous versions of the manuscript. All authors have read and approved the final version of the manuscript. Data availabilityAll data are provided in the manuscript. ReferencesAbreu-Grobois, A. and Plotkin, P. 2008. (IUCN SSC Marine Turtle Specialist Group) Lepidochelys olivacea. The IUCN Red List of Threatened Species 2008: e. T11534A3292503 Available via https://dx.doi.org/10.2305/IUCN.UK.2008.RLTS.T11534A3292503.en (Accessed 13th February 2025). Aguirre, A.A., O’Hara, T.M., Spraker, T.R. and Jessup, D.A. 2002. Monitoring the health and conservation of marine mammals, sea turtles, and their ecosystems (pp. 79–94). New York, NY: Oxford University Press, pp: 79–94. Alfaro, A., Køie, M. and Buchmann, K. 2008. Synopsis of infections in sea turtles caused by virus, bacteria and parasites: an ecological review. In 27th annual symposium on sea turtle biology and conservation. NOAA Tech Memo. Ariano-Sánchez, D., Nesthus, A., Rosell, F. and Reinhardt, S. 2023. Developed black beaches – too hot to emerge? Factors affecting sand temperatures at nesting grounds of olive ridley sea turtles (Lepidochelys olivacea). J. Eco. Chg. 5, 100074; doi:10.1016/j.ecochg.2023.100074 Arpini, C., Nóbrega, Y., Castheloge, V., Neves, D., Tadokoro, C., Da Costa, G., Oliveira, M. and De Deus Santos, M. 2019. Purpureocillium lilacinum infection in captive loggerhead sea turtle hatchlings. Med. Mycol. Case Rep. 23, 8–11; doi:10.1016/j.mmcr.2018.10.002 Balajee, S.A., Borman, A.M., Brandt, M.E., Cano, J., Cuenca-Estrella, M., Dannaoui, E., Guarro, J., Haase, G., Kibbler, C.C., Meyer, W., O'Donnell, K., Petti, C.A., Rodriguez-Tudela, J.L., Sutton, D., Velegraki, A. and Wickes, B.L. 2009. Sequence-based identification of Aspergillus, Fusarium, and Mucorales species in the clinical mycology laboratory: where are we and where should we go from here?. J. Clin. Microbiol. 47(4), 877–884; doi:10.1128/jcm.01685-08 Becker, D.J., Streicker, D.G. and Altizer, S. 2015. Linking anthropogenic resources to wildlife–pathogen dynamics: a review and meta-analysis. Eco. Letts. 18(5), 483–495; doi:10.1111/ele.12428 Bengis, R.G., Leighton, F.A., Fischer, J.R., Artois, M., Mörner, T. and Tate, C.M. 2004. The role of wildlife in emerging and re-emerging zoonoses. Rev. Scient. Tech. Off. Int. Epiz. 23(2), 497–512. Binhammer, M.R., Beange, M. and Arauz, R. 2019. Sand temperature, sex ratios, and nest success in olive ridley sea turtles. Mar. Turt. Newsl. 159, 5–9. Bowen, B.W., Clark, A.M., Abreu-Grobois, F.A., Chaves, A., Reichart, H.A. and Ferl, R.J. 1997. Global phylogeography of the ridley sea turtles (Lepidochelys spp.) as inferred from mitochondrial DNA sequences. Gen 101(3), 179–189; doi:10.1023/A:1018382415005 Cabañes, F.J., Alonso, J.M., Castellá, G., Alegre, F., Domingo, M. and Pont, S. 1997. Cutaneous hyalohyphomycosis caused by Fusarium solani in a loggerhead sea turtle (Caretta caretta L.). J. Clin. Microbiol. 35(12), 3343–3345; doi:10.1128/jcm.35.12.3343-3345.1997 Cáceres-Farias, L., Reséndiz, E., Espinoza, J., Fernández-Sanz, H. and Alfaro-Núñez, A. 2022. Threats and vulnerabilities for the globally distributed olive ridley (Lepidochelys olivacea) sea turtle: a historical and current status evaluation. Animals 12, 1837. Carpena-Catoira, C., Ortega-Ortiz, C.D., Liñán-Cabello, M.A., Olivos-Ortiz, A. and Elorriaga-Verplancken, F.R. 2022. Foraging ecology of the olive ridley sea turtle (Lepidochelys olivacea) from the Mexican Central Pacific based on stable isotopes. Reg. Stud. Mar. Sci. 52, 102296; doi:10.1016/j.rsma.2022.102296 Casale, P. 2011. Sea turtle by-catch in the Mediterranean. Fish Fisheries 12(3), 299–316; doi:10.1111/j.1467-2979.2010.00394.x Casale, P., Affronte, M., Insacco, G., Freggi, D., Vallini, C., Pino D'astore, P., Basso, R., Paolillo, G., Abbate, G. and Argano, R. 2010. Sea turtle strandings reveal high anthropogenic mortality in Italian waters. Aquatic Conserv. Mar. Freshwater Ecosyst. 20(6), 611–620; doi:10.1002/aqc.1133 Centers for Disease Control and Prevention. 2008. Guideline for disinfection and sterilization in healthcare facilities. U.S. Department of Health & Human Services. Available via https://www.cdc.gov/infection-control/media/pdfs/guideline-disinfection-h.pdf Chai, C.X., Samat, A., Mohd-Taib, F.S., Bharudin, I. and Tim, J. 2023. Fungal infection of sea turtle eggs in the sea turtle hatcheries in Peninsular Malaysia. Fun. Ec. 63, 101243. Convention on Migratory Species (CMS). 2014. Lepidochelys olivacea. Available via https://www.cms.int/es/species/lepidochelys-olivacea Crespo-Picazo, J.L., García-Parraga, D., Domènech, F., Tomás, J., Aznar, F.J., Ortega, J. and Corpa, J.M. 2017. Parasitic outbreak of the copepod Balaenophilus manatorum in neonate loggerhead sea turtles (Caretta caretta) from a head-starting program. BMC Vet. Res. 13(1), 154; doi:10.1186/s12917-017-1074-8 Donnelly, K., Waltzek, T., Wellehan, J., Sutton, D., Wiederhold, N. and Stacy, B. 2015. Phaeohyphomycosis resulting in obstructive tracheitis in three green sea turtles Chelonia mydas stranded along the Florida coast. Dis. Aquat. Organ. 113, 257–262; doi:10.3354/dao02843 Donnelly, K., Waltzek, T.B., Wellehan, J.F.X., Stacy, N.I., Chadam, M. and Stacy, B.A. 2016. Mycobacterium haemophilum infection in a juvenile leatherback sea turtle (Dermochelys coriacea). J. Vet. Diag. Inv. 28(6), 718–721; doi:10.1177/1040638716661746 Faust, C.L., Mccallum, H.I., Bloomfield, L.S.P., Gottdenker, N.L., Gillespie, T.R., Torney, C.J., Dobson, A.P. and Plowright, R.K. 2018. Pathogen spillover during land conversion. Eco. Letts. 21(4), 471–483; doi:10.1111/ele.12904 Garcia-Hartmann, M., Hennequin, C., Catteau, S., Béatini, C. and Blanc, V. 2017. Clusters of Fusarium solani infection in juvenile captive born Caretta caretta sea turtles. J. Mycol. Med. 27, 113–118; doi:10.1016/j.mycmed.2016.12.001 George, R. 1996. Health problems and diseases of sea turtles. In The biology of sea turtles. Eds., Lutz. and Musick. Boca Raton, FL: CRC Press, pp: 363–85. https://doi.org/10.1201/9780203737088 Gleason, F., Allerstorfer, M. and Lilje, O. 2020. Newly emerging diseases of marine turtles, especially sea turtle egg fusariosis (STEF) caused by species in the Fusarium solani complex (FSSC). Mycology 11(3), 184–194; doi:10.1080/21501203.2019.1710303 Greene, W., Chan, B., Bromage, E., Grose, J.H., Walsh, C., Kortright, K., Forrest, S., Perry, G., Byrd, L. and Stamper, M.A. 2021. The use of bacteriophages and immunological monitoring for the treatment of a case of chronic septicemic cutaneous ulcerative disease in a loggerhead sea turtle (Caretta caretta). J. Aq. Ani. Health 33(3), 139–154; doi:10.1002/aah.10130 Harrison, T.S. 2017. Systemic fungal infections. Med 45(12), 757–762; doi:10.1016/j.mpmed.2017.09.007 Hartzheim, A.M., Terry, J.L., Field, E.K., Haydt, N.T., Poo, S. and Neuman-Lee, L.A. 2023. Immune and stress physiology of two captively-housed tortoise species. J. Exp. Zool. Part A. Ecol. Integr. Physiol. 339(2), 220–233; doi:10.1002/jez.2674 Hatase, H., Omuta, K., Itou, K. and Komatsu, T. 2013. Effect of maternal foraging habitat on offspring quality in the loggerhead sea turtle (Caretta caretta). Ecol. Evol. 750, 167–179; doi:10.1002/ece3.3938 Hernández Pelén, S. 2020. Determinación de la presencia de hongos del género Fusarium en nidos de Lepidochelys olivacea (Doctoral dissertation, Universidad de San Carlos de Guatemala). Hunt, C. 2019. Stress and welfare. In Mader's Reptile and amphibian medicine and surgery. > Ed. Mader, D.R. Elsevier, St. Louis, MO, Instituto Nacional de Higiene "Rafael Rangel". 2017. Ficha técnica: Agua estéril para inyección. Available via https://inhrr.gob.ve/fichasfarma/archivos/20170117110326_2407.pdf Khafagy, A., Kamel, A., Abouelgheit, S., Abu-Elala, N., Eidaros, N. and Abdelrazeq, F. 2023. Bacteriological studies on sea turtles in suez governorate. Suez Canal Vet. Med. J. 28(2), 485–494; doi:10.21608/scvmj.2024.241450.1149 Kuschke, S., Perrault, J. and Wyneken, J. 2024a. Turning up the heat on sea turtles. In SWOT Report, Vol 19. The State of the World's Sea Turtles. Available via https://www.seaturtlestatus.org Kuschke, S.G., Wyneken, J. and Miller, D. 2024b. Baseline skin microbiota of the leatherback sea turtle. Microorganisms 12, 925; doi:10.3390/microorganisms12050925 Kuschke, S.G., Wyneken, J., Cray, C., Turla, E., Kinsella, M. and Miller, D.L. 2023. Fusarium spp. an emerging fungal threat to leatherback (Dermochelys coriacea) eggs and neonates. Front. Mar. Sci. 10, 1170376; doi:10.3389/fmars.2023.1170376 Lai, O., Tinelli, A., Soloperto, S., Marzano, G., Tosches, M., Leone, R., Gelli, D., Belloli, C. and Crescenzo, G. 2020. Fusarium solani hyalohyphomycosis in loggerhead sea turtles (Caretta caretta): a diagnostic and therapeutical challenge. Vet. It. 56(2), 123–132; doi:10.12834/VetIt.2035.13422.1 Laloë, J.O., Esteban, N., Berkel, J. and Hays, G.C. 2016. Sand temperatures for nesting sea turtles in the Caribbean: implications for hatchling sex ratios in the face of climate change. J. Exp. Mar. Bio. Eco. 474, 92–99; doi:10.1016/j.jembe.2015.09.015 Leineweber, C., Müller, E. and Marschang, R.E. 2021. Herpesviruses in captive Chelonians in Europe between 2016 and 2020. Fr. Vet. Sci. 8, 733299; doi:10.3389/fvets.2021.733299 Lolavar, A. and Wyneken, J. 2020. The impact of sand moisture on the temperature-sex ratio responses of developing loggerhead (Caretta caretta) sea turtles. Zoology 138, 125739; doi:10.1016/j.zool.2019.125739 Luangsa-Ard, J., Houbraken, J., Van Doorn, T., Hong, S.B., Borman, A.M., Hywel-Jones, N.L. and Samson, R.A. 2011. Purpureocillium, a new genus for the medically important Paecilomyces lilacinus. FEMS Microbiol. Lett. 321, 141–149; doi:10.1111/j.1574-6968.2011.02322.x Manire, C., Rhinehart, H., Sutton, D., Thompson, E., Rinaldi, M., Buck, J. and Jacobson, E. 2002. Disseminated mycotic infection caused by Colletotrichum acutatum in a Kemp’s ridley sea turtle (Lepidochelys kempii). J. Clin. Microbiol. 40, 4273–4280; doi:10.1128/jcm.40.11.4273-4280.2002 Martins, S., Patino−Martinez, J., Abella, E., De Santos Loureiro, N., Clarke, L.J. and Marco, A. 2022. Potential impacts of sea level rise and beach flooding on reproduction of sea turtles. Clim. Chan. Eco. 3, 100053; doi:10.1016/j.ecochg.2022.100053 Mashkour, N., Jones, K., Kophamel, S., Hipolito, T., Ahasan, S., Walker, G., Jakob-Hoff, R., Whittaker, M., Hamann, M., Bell, I., Elliman, J., Owens, L., Saladin, C., Crespo-Picazo, J.L., Gardner, B., Loganathan, A.L., Bowater, R., Young, E., Robinson, D., Baverstock, W., Blyde, D., March, D., Eghbali, M., Mohammadi, M., Freggi, D., Giliam, J., Hale, M., Nicolle, N., Spiby, K., Wrobel, D., Parga, M., Mobaraki, A., Rajakaruna, R., Hyland, K.P., Read, M. and Ariel, E. 2020. Disease risk analysis in sea turtles: a baseline study to inform conservation efforts. PLos One 15(10), 230760. Mohsen, L.Y., Al-Janabi, J.K.A. and Jebor, M.A. 2016. The effect of some environmental conditions on the growth and activity of the external enzymes for five species of Fusarium. J. Babylon University/Pure. Appl. Sci. 24(3), 630–646; doi:10.29196/jbuaps.v24i3.1023 Morales-Mérida, B.A., Muccio, C. and Girondot, M. 2023. Validating trends in olive ridley sea turtle nesting track counts in Guatemala in light of a national hatchery protection strategy. Oryx 57(1), 48–54; doi:10.1017/S0030605322000382 Nardoni, S. and Mancianti, F. 2023. Mycotic diseases in chelonians. J. Fun. 9(5), 518; doi:10.3390/jof9050518 Nash, A. and Ryan, E.J. 2023. Immunity in sea turtles: review of a host-pathogen arms race millions of years in the running. Ani 13(4), 556; doi:10.3390/ani13040556 Nursyam, H., Fajar, M., Qurrota, A. and Airfin, N.B. 2016. Survey of fungus and parasites content found in ridley turtles (Lepidochelys olivacea) at Serang beach, Blitar regency, East Java. Eco. Env. &. Cons. 22(4), 175–180. Pietroluongo, G., Centelleghe, C., Sciancalepore, G., Ceolotto, L., Danesi, P., Pedrotti, D. and Mazzariol, S. 2023. Environmental and pathological factors affecting the hatching success of the two northernmost loggerhead sea turtle (Caretta caretta) nests. Sci. Rep. 13(1), 2938; doi:10.1038/s41598-023-30211-z Poloczanska, E.S., Brown, C.J., Sydeman, W.J., Kiessling, W., Schoeman, D.S., Moore, P.J., Brander, K., Bruno, J.F., Buckley, L.B., Burrows, M.T., Duarte, C.M., Halpern, B.S., Holding, J., Kappel, C.V., O’Connor, M.I., Pandolfi, J.M., Parmesan, C., Schwing, F., Thompson, S.A. and Richardson, A.J. 2013. Global imprint of climate change on marine life. Nat. Cli. Ch. 3(10), 919–925; doi:10.1038/nclimate1958 Pörtner, H.O. and Gutt, J. 2016. Impacts of climate variability and change on (marine) animals: physiological underpinnings and evolutionary consequences. Int. Comp. Bio. 56(1), 31–44; doi:10.1093/icb/icw019 Poti, M., Long, S., Rusli, M., Mohd Jani, J., Hugé, J. and Dahdouh-Guebas, F. 2021. Changing trends and perceptions of sea turtle egg consumption in Redang Island, Malaysia. Eco. Soc. 26(4), 14; doi:10.5751/ES-12717-260414 Praja, R., Yudhana, A., Haditanojo, W., Kusumawardani, A., Putri, A., Fadillah, I., Pratama, L. and Afiyah, N. 2023. A Short Note on Fusarium spp. Identification from eggs of olive ridley sea turtle (Lepidochelys olivacea) in Banyuwangi, East Java, Indonesia. Ind. Vet. J. 100(5), 19–22. Rhodin, A.G.J., Stanford, C.B., Van Dijk, P.P., Eisemberg, C., Luiselli, L., Mittermeier, R.A., Hudson, R., Horne, B. D., Goode, E.V., Kuchling, G., Walde, A., Baard, E.H.W., Berry, K.H., Bertolero, A., Blanck, T.E.G., Bour, R., Buhlmann, K.A., Cayot, L.J., Collett, S., Currylow, A., Das, I., Diagne, T., Ennen, J.R., Forero-Medina, G., Frankel, M.G., Fritz, U., García, G., Gibbons, J.W., Gibbons, P.M., Gong, S., Guntoro, J., Hofmeyr, M.D., Iverson, J.B., Kiester, A.R., Lau, M., Lawson, D P., Lovich, J.E., Moll, E.O., Páez, V.P., Palomo-Ramos, R., Platt, K., Platt, S.G., Pritchard, P.C.H., Quinn, H.R., Rahman, S.C., Randrianjafizanaka, S.T., Schaffer, J., Selman, W., Shaffer, H.B., Sharma, D.S.K., Shi, H., Singh, S., Spencer, R., Stannard, K. and Sutcliffe, S. Thomson, S., Vogt, R.C. and Walde, A 2018. Global conservation status of turtles and tortoises (order testudines). Chelonian Conserv. Biol. 17, 135; doi:10.2744/CCB-1348.1 Rodríguez-Prieto, V., Vicente-Rubiano, M., Sánchez-Matamoros, A., Rubio-Guerri, C., Melero, M., Martínez-López, B. and Sánchez-Vizcaíno, J.M. 2015. Systematic review of surveillance systems and methods for early detection of exotic, new and re-emerging diseases in animal populations. Epidemiol. Infection 143(10), 2018–2042; doi:10.1017/S095026881400212X Sáenz, V., Alvarez-Moreno, C., Pape, P., Restrepo, S., Guarro, J. and Ramírez, A. 2020. A one health perspective to recognize Fusarium as important in clinical practice. J. Fun. 6(4), 235; doi:10.3390/jof6040235 Sagasiousman, R. and Khairani, S. 2021. Microbial isolations from olive ridley sea turtle (Lepidochelys olivacea) in Alas Purwo national park, Indonesia. In Proceeding of the 10th International Seminar and 12th Congress of Indonesian Society for Microbiology (ISISM 2019), Dordrecht, The Netherlands: Atlantis Press, pp 189–194. doi:10.2991/absr.k.210810.033 Santos, R.G., Martins, A.S., Farias, J.D.N., Horta, P.A., Pinheiro, H.T., Torezani, E., Baptistotte, C., Seminoff, J.A., Balazs, G.H. and Work, T.M. 2011. Coastal habitat degradation and green sea turtle diets in Southeastern Brazil. Mar. Poll. Bull. 62(6), 1297–1302; doi:10.1016/j.marpolbul.2011.03.004 Sarmiento-Ramírez, J.M., Abella-Pérez, E., Phillott, A.D., Sim, J., Van West, P., Martín, M.P., Marco, A. and Diéguez-Uribeondo, J. 2014. Global distribution of two fungal pathogens threatening endangered sea turtles. PLos One 9(1), e85853; doi:10.1371/journal.pone.0085853 Shanker, K., Abreu-Grobois, A., Bezy, V., Briseno, R., Colman, L., Girard, A., Girondot, M., Jensen, M.P., Manoharakrishnan, M., Rguez-Baron, J.M., Valverde, R. and West, L. 2021. Olive ridleys: the quirky turtles that conquered the world. In State of the World’s Sea Turtles Report (SWOT); Western Pacific Regional Fishery Management Council: Honolulu, HI. Available via http://www. SeaTurtleStatus.org Shourie, A., Singh, R. and Singh, A. 2021. Common fungal infections in reptiles and their diagnosis. In Fungal diseases in animals from infections to prevention. Springer, Cham, p: 82. Stacy, B., Pessier, A. and Ossiboff, R. 2021. Host response to infectious agents and identification of pathogens in tissues sections. In Infectious Diseases and Pathology of Reptiles, Color atlas and text. Jacobson. and Garner, CRC Press, Boca Raton, FL, pp: 375–422. Stanford, C.B., Iverson, J.B., Rhodin, A.G.J., van Dijk, P.P., Mittermeier, R.A., Kuchling, G., Berry, K.H., Bertolero, A., Bjorndal, K.A., Blanck, T.E.G., Buhlmann, K.A., Burke, R.L., Congdon, J.D. Diagne, T., Edwards, T., Eisemberg, C.C., Ennen, J.R., Forero-Medina, G., Frankel, M., Fritz, U., Gallego-García, N., Georges, A., Gibbons, J.W., Gong, S., Goode, E.V., Shi, H.T., Hoang, H., Hofmeyr, M.D., Horne, B.D., Hudson, R., Juvik, J.O., Kiester, R.A., Koval, P., Le, M., Lindeman, P.V., Lovich, J.E., Luiselli, L., McCormack, T.E.M., Meyer, G.A., Páez, V.P., Platt, K., Platt, S.G., Pritchard, P.C.H., Quinn, H.R., Roosenburg, W.M., Seminoff, J.A., Shaffer, H.B., Spencer, R., Van Dyke, J.U., Vogt, R.C. and Walde, A.D. 2020. Turtles and tortoises are in trouble. Curr. Biol. 30, R721–R735; doi:10.1016/j.cub.2020.04.088 Thomson, J.A., Burkholder, D., Heithaus, M.R. and Dill, L.M. 2009. Validation of a rapid visual-assessment technique for categorizing the body condition of green turtles (Chelonia mydas) in the field. Copeia 2009 (2), 251–255; doi:10.1643/CE-07-227 Tisdell, C. and Wilson, C. 2005. Perceived impacts of ecotourism on environmental learning and conservation: turtle watching as a case study. Env. Dev. Sust. 7, 291–302; doi:10.1007/s10668-004-7619-6 Tomillo, P.S., Saba, V.S., Piedra, R., Paladino, F.V. and Spotila, J.R. 2008. Effects of illegal harvest of eggs on the population decline of leatherback turtles in Las Baulas Marine National Park, Costa Rica. Cons. Bio. 22(5), 1216–1224; doi:10.1111/j.1523-1739.2008.00987.x Vyzantiadis, T.A., Johnson, E.M. and Kibbler, C.C. 2012. From the patient to the clinical mycology laboratory: how can we optimize microscopy and culture methods for mold identification?. J. Cli. Pat. 65(6), 475–483; doi:10.1136/jclinpath-2011-200601 Walsh, T.J., Hayden, R.T. and Larone, D.H. 2018. Identification of fungi in culture. In Larone’s medically important fungi. Eds., Walsh, R.T. and Larone, H. ASM Press, Washington, DC. https://doi.org/10.1128/9781555819880.ch2 Wang, W.-L., Sun, P.-L., Kao, C.-F., Li, W.-T., Cheng, I.-J., Yu, P.-H. 2021. Disseminated candidiasis and candidemia caused by Candida palmioleophila in a green sea turtle (Chelonia mydas). Animal 11, 3480. Wei See, K. and Abdul Latip, N.S. 2023. Fusarium solani species complex (FSSC) in nests of hawksbill turtles (Eretmochelys imbricata) with high hatching success in Melaka, Malaysia. Pertanika J. Sci. Tech. 31(5), 2601–2619; doi:10.47836/pjst.31.5.29 Williams, S.R., Sims, M.A., Roth-Johnson, L. and Wickes, B. 2012. Surgical removal of an abscess associated with Fusarium solani from a Kemp’s ridley sea turtle (Lepidochelys kempii). J. Zoo Wildl. Med. 43, 402–406; doi:10.1638/2011-0102.1 World Health Organization. 2023 One Health. Available via https://www.who.int/health-topics/one-health#tab=tab_1 (Accessed 29th March, 2025). | ||
| How to Cite this Article |
| Pubmed Style Figueroa LS, Escobar J, Yllescas M. Prevalence of Fusarium sp. in juvenile olive ridley sea turtles (Lepidochelys olivacea) kept at the Centro de Conservación Marina, Taxisco, Santa Rosa, Guatemala. Open Vet. J.. 2025; 15(10): 5097-5107. doi:10.5455/OVJ.2025.v15.i10.27 Web Style Figueroa LS, Escobar J, Yllescas M. Prevalence of Fusarium sp. in juvenile olive ridley sea turtles (Lepidochelys olivacea) kept at the Centro de Conservación Marina, Taxisco, Santa Rosa, Guatemala. https://www.openveterinaryjournal.com/?mno=217723 [Access: January 25, 2026]. doi:10.5455/OVJ.2025.v15.i10.27 AMA (American Medical Association) Style Figueroa LS, Escobar J, Yllescas M. Prevalence of Fusarium sp. in juvenile olive ridley sea turtles (Lepidochelys olivacea) kept at the Centro de Conservación Marina, Taxisco, Santa Rosa, Guatemala. Open Vet. J.. 2025; 15(10): 5097-5107. doi:10.5455/OVJ.2025.v15.i10.27 Vancouver/ICMJE Style Figueroa LS, Escobar J, Yllescas M. Prevalence of Fusarium sp. in juvenile olive ridley sea turtles (Lepidochelys olivacea) kept at the Centro de Conservación Marina, Taxisco, Santa Rosa, Guatemala. Open Vet. J.. (2025), [cited January 25, 2026]; 15(10): 5097-5107. doi:10.5455/OVJ.2025.v15.i10.27 Harvard Style Figueroa, L. S., Escobar, . J. & Yllescas, . M. (2025) Prevalence of Fusarium sp. in juvenile olive ridley sea turtles (Lepidochelys olivacea) kept at the Centro de Conservación Marina, Taxisco, Santa Rosa, Guatemala. Open Vet. J., 15 (10), 5097-5107. doi:10.5455/OVJ.2025.v15.i10.27 Turabian Style Figueroa, Luis S., Jacqueline Escobar, and Martín Yllescas. 2025. Prevalence of Fusarium sp. in juvenile olive ridley sea turtles (Lepidochelys olivacea) kept at the Centro de Conservación Marina, Taxisco, Santa Rosa, Guatemala. Open Veterinary Journal, 15 (10), 5097-5107. doi:10.5455/OVJ.2025.v15.i10.27 Chicago Style Figueroa, Luis S., Jacqueline Escobar, and Martín Yllescas. "Prevalence of Fusarium sp. in juvenile olive ridley sea turtles (Lepidochelys olivacea) kept at the Centro de Conservación Marina, Taxisco, Santa Rosa, Guatemala." Open Veterinary Journal 15 (2025), 5097-5107. doi:10.5455/OVJ.2025.v15.i10.27 MLA (The Modern Language Association) Style Figueroa, Luis S., Jacqueline Escobar, and Martín Yllescas. "Prevalence of Fusarium sp. in juvenile olive ridley sea turtles (Lepidochelys olivacea) kept at the Centro de Conservación Marina, Taxisco, Santa Rosa, Guatemala." Open Veterinary Journal 15.10 (2025), 5097-5107. Print. doi:10.5455/OVJ.2025.v15.i10.27 APA (American Psychological Association) Style Figueroa, L. S., Escobar, . J. & Yllescas, . M. (2025) Prevalence of Fusarium sp. in juvenile olive ridley sea turtles (Lepidochelys olivacea) kept at the Centro de Conservación Marina, Taxisco, Santa Rosa, Guatemala. Open Veterinary Journal, 15 (10), 5097-5107. doi:10.5455/OVJ.2025.v15.i10.27 |